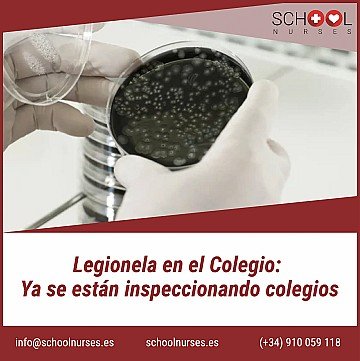
Press Release cover image

Por fin, tras varios meses de retraso, se publica el esperado Real Decreto 614/2024, de 2 de julio, por el que se modifica el Real Decreto 487/2022, de 21 de junio, por el que se establecen los requisitos sanitarios para la prevención y el control de la legionelosis
Aunque la mayoría de los puntos que modifica este Real Decreto ya se habían tenido en cuenta en la implantación de los Planes de Control de Legionella en los establecimientos hoteleros, esta publicación da validez jurídica a estos puntos.
A continuación resumimos los cambios más relevantes que supone este Real Decreto de impacto directo en los alojamientos turísticos:
- La toma de muestras para la determinación de Legionella mediante cultivo será realizada por una entidad o empresa acreditada para el acto de la toma de muestra de acuerdo con la Norma UNE-EN-ISO/IEC 17025:2017 (requisito obligatorio a partir del 1-ene-2030
- Ya no será exigible que toda el agua recirculada en un sistema ACS alcance obligatoriamente los 60ºC. Es decir, se permite el uso de válvulas mezcladoras tras la salida de los sistemas de producción ACS.
- En cuanto a las revisiones trimestrales de los acumuladores, que en la anterior versión establecía obligación de limpieza y desinfección, en el actual redactado se establece que la revisión del estado de mantenimiento de los depósitos acumuladores se realizará trimestralmente, sin que ello implique obligatoriamente realizar la apertura y vaciado de los mismos.
- En el procedimiento de limpieza y desinfección de vasos de hidromasaje y similares ya no es obligatorio el requerimiento de vaciado de la instalación (con la consecuente pérdida de agua). No obstante, la redacción queda ambigua ya que sustituye la obligatoriedad por el término “cuando sea necesario para evitar o reducir al mínimo la probabilidad de proliferación y diseminación de Legionella”. En este punto, solicitaremos a la autoridad sanitaria que defina en lo posible los procedimientos a seguir según los casos.
- En los procedimientos de muestreo de Legionella en sistemas de agua sanitaria se introducen los siguientes cambios:
- No se requiere tomar muestra en los puntos medios de la instalación.
- Para establecimientos con 10 o menos puntos terminales en ACS se deberán tomar una sola muestra en vez de tres.
- Se confirma que en alojamientos turísticos la unidad alojativa se contabilizará como un único punto terminal de cara a estimar el número de muestras representativas.
- Solo será necesario analizar el parámetro hierro en las muestras si el sistema dispone de partes metálicas que contienen hierro en su composición.
- En cuanto a los muestreos de instalaciones de baño de hidromasaje y similares, y que estén afectadas por la normativa de piscinas (RD 742/2013), se analizarán exclusivamente los parámetros de dicha normativa. Por tanto, no deberán analizarse aerobios en dichas instalaciones.
- En certificados oficiales de Limpieza y Desinfección sólo deberá detallarse los niveles de temperatura y biocidas alcanzados en los puntos terminales distales y no en todos.
En lo referente a los depósitos de acumulación entre 250 y 750 litros y los interacumuladores de doble tanque con volumen de acumulación de agua inferiores a 750 litros, de instalaciones de agua caliente sanitaria (ACS) y requisitos de accesos para inspección, limpieza, vaciado y toma de muestras, vamos a solicitar a las autoridades sanitarias la correcta interpretación de los requisitos solicitados y plazos para la sustitución de las instalaciones que no los cumplieran.